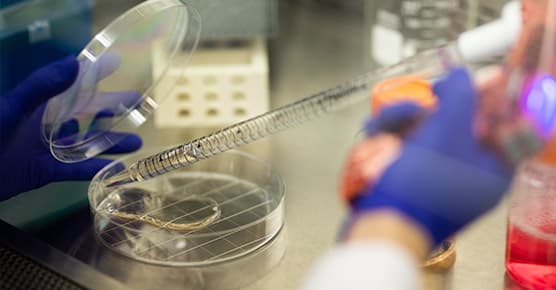
A laboratory setting showing a Petri dish. We’re a leading academic medical center with an integrated research and clinical care approach.

At the Forefront of Cancer Care
If you have been diagnosed with cancer, where and how you start your care matters.
A second opinion from UChicago Medicine cancer experts can empower you with knowledge about your diagnosis and your treatment options, including therapies not widely available at most hospitals.
Ultimately, this can give you confidence about your care, provide a sense of control and help alleviate anxiety during a stressful time.
Why Get a Second Opinion at the UChicago Medicine Comprehensive Cancer Center?

Teams of Cancer Experts
You'll have access to doctors who specialize in your type of cancer. In fact, we have more than 200 physicians and scientists on our cancer team, with highly skilled support staff to match.

Nationally Recognized Cancer Care
We're one of only two NCI-designated Comprehensive Cancer Centers in Illinois — the gold standard for cancer programs that is earned by the nation's top cancer centers.
Cancer Research & Clinical Trials
We’re a leading academic medical center with an integrated research and clinical care approach. That means you benefit from advanced technologies, resources and therapies other hospitals may not have.

Convenient Chicagoland Care
You and your family won’t be far from home during treatment. UChicago Medicine offers top-tier cancer care services at several locations throughout the Chicago region.

